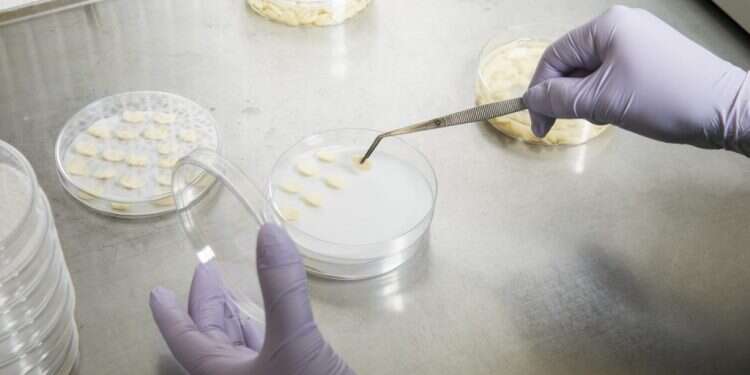
עיבוד דגימות מזון במעבדה של Calyxt. צילום: Tim Gruber for The Washington Post צילום: Tim Gruber for The Washington Post

מהפכה מתחוללת בעריכת גנים – ובראשה עומד דייוויד ליו, ביולוג מולקולרי אמריקני שעבודתו פורצת הדרך משכתבת את אבני הבניין של החיים בדיוק חסר תקדים. ליו, פרופסור במכון ברוד של MIT והרווארד, זכה בשבת בפרס "פריצת הדרך" במדעי החיים על פיתוח שתי טכנולוגיות מהפכניות: אחת שכבר משפרת את חייהם של חולים במחלות גנטיות חמורות, ואחרת שעשויה לשנות את פני הרפואה בשנים הקרובות.
הוא שוחח עם AFP לקראת טקס הענקת הפרס הנחשב, שנוסד בעמק הסיליקון ומתקיים בלוס אנג'לס. הוא יקבל 3 מיליון דולר על עבודתו בתחום "עריכת בסיס" ו"עריכת פריים", ומתכנן לתרום את רוב הסכום לתמיכה בקרן הצדקה שלו. "היכולת לשנות רצף DNA לבחירתנו לרצף אחר לבחירתנו היא יכולת חזקה באופן בסיסי מאוד", אמר בן ה-51, וחזה שימושים לא רק ברפואה האנושית אלא גם בפיתוח יבולים מזינים יותר או עמידים למחלות.
תיקון הקוד
ה-DNA מורכב מארבע "אותיות" כימיות – בסיסי הנוקלאוטידים A, G, T ו-C. מוטציות ברצף הזה גורמות לאלפי מחלות אנושיות, ועד לאחרונה, עריכת גנים יכלה לתקן רק מספר מוגבל מהן. אפילו CRISPR-Cas9, הטכנולוגיה פורצת הדרך שזיכתה את מפתחיה בפרס נובל ב-2020, מוגבלת מאוד. היא חותכת את שני גדילי סליל ה-DNA, מה שהופך אותה לשימושית בעיקר לשיבוש גנים ולא לתיקונם, והתהליך עלול ליצור שגיאות חדשות.
"כדי להשתמש בעריכת גנום לטיפול במחלות גנטיות, יש צורך בדרך כלל לתקן שגיאת כתיב ב-DNA, לא רק לשבש גן", אמר ליו. תובנה זו הובילה את מעבדתו לפתח את טכנולוגיית עריכת הבסיסים, שמשתמשת בחלבון Cas9 – מנוטרל כך שלא יוכל לחתוך את שני גדילי ה-DNA – כדי לאתר רצף DNA ממוקד, ובאנזים נוסף כדי להמיר אות אחת באחרת – לדוגמה, מ-C ל-T או מ-G ל-A.

ההיפוך – מ-T ל-C או מ-A ל-G – היה קשה יותר. צוותו של ליו התגבר על האתגר באמצעות הנדסה של אנזימים חדשים לגמרי. כיום, עורכי הבסיסים מסוגלים לתקן כ-30 אחוז מהמוטציות הגורמות למחלות גנטיות. הטכנולוגיה כבר נמצאת בלפחות 14 ניסויים קליניים. באחד מהם, חברת Beam Therapeutics – שליו היה ממייסדיה – הודיעה כי טיפלה בחולי AATD, מחלה גנטית נדירה הפוגעת בריאות ובכבד, באמצעות עירוי תרופה אחת בלבד.
בעוד שתרפיות גנטיות מסורתיות נוטות לשבש גנים פגומים או לעקוף אותם, עריכת הבסיסים מתקנת את המוטציה עצמה. "זוהי הפעם הראשונה שבני אדם תיקנו מוטציה שגורמת למחלה גנטית אצל מטופל", אמר ליו.
תקווה לחולי סיסטיק פיברוזיס
עריכת הבסיסים, שכונתה במהרה "CRISPR 2.0", אינה יכולה לתקן כל מוטציה. כ-70 אחוז מתוך כ-100,000 המוטציות הידועות הגורמות למחלות – אינן ניתנות לתיקון בשיטה זו, ובכלל זה מוטציות הנגרמות על ידי אותיות חסרות או עודפות. כדי להרחיב את ארגז הכלים, מעבדתו של ליו הציגה ב-2019 את עריכת הפריים – שיטה היכולה להחליף מקטעים שלמים של DNA פגום ברצפים מתוקנים.

אם CRISPR הוא כמו מספריים שחותכים DNA, ועורכי הבסיסים הם כמו עיפרון שמתקן אותיות בודדות, אז עריכת הפריים היא המקבילה של פונקציית "חיפוש והחלפה" במעבד תמלילים. יצירת הכלי הזה דרשה סדרת פריצות דרך שליו וצוותו תיארו כ"ניסים קטנים". התוצאה היא, לדבריו, "הדרך הרב-שימושית ביותר הידועה לנו לערוך את הגנום האנושי". בין המחלות אותן ליו וצוותו מנסים לרפא באמצעות עריכת פריים: סיסטיק פיברוזיס – מחלה גנטית נפוצה שנגרמת לרוב בשל שלוש אותיות חסרות ב-DNA, וגורמת להצטברות ריר סמיך בריאות ובמערכת העיכול.
המעבדה של ליו הפכה חלק גדול מעבודתה לזמינה לציבור, ושיתפה את תוכניות ה-DNA דרך מאגר נתונים ללא מטרת רווח המשמש עשרות אלפי מעבדות ברחבי העולם. "המדע שאנחנו יוצרים – אשר ממומן בסופו של דבר על ידי החברה, דרך ממשלות ותורמים – צריך לחזור ולהועיל לחברה", אמר.